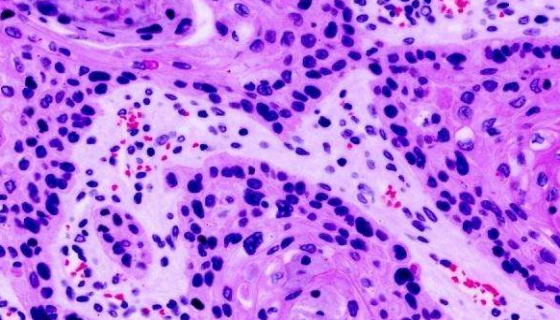
NCI-H446 人小细胞肺癌细胞的应用！
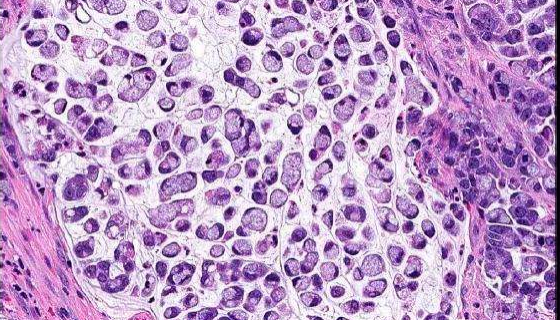
人胃腺癌细胞的培养步骤与应用！

用于有机化工废水处理的:微杆菌属
微杆菌属,在幼龄培养物中细胞呈细长、不规则的杆菌,0.4~0...

大肠埃希氏菌的感染途径与症状及防御与治疗!
大肠埃希氏菌是肠道正常菌群的主要组成,在人类生存环境中无处不...

铜绿假单胞菌是什么?对人体有什么危害?
铜绿假单胞菌是一种常见的革兰氏阴性杆菌,该菌为专性需氧菌,生...

浸麻类芽孢杆菌的特点与优势及保藏方法!
浸麻类芽孢杆菌,仅用于科学研究或者工业应用等非医疗目的不可用...

根癌土壤杆菌的生物特性与传播途径及防疫方法!
根癌土壤杆菌,根瘤菌科土壤杆菌属真菌。寄主范围非常广,有几百...

向日葵茎溃疡病菌的形态特征与主要价值!
向日葵茎溃疡病菌是Diaporthe属的微生物,原产地为中国...
NCI-H446 人小细胞肺癌细胞的应用!
NCI-H446人小细胞肺癌细胞是从一位小细胞肺癌患者的胸水...
人胃腺癌细胞的培养步骤与应用!
人胃腺癌细胞源自一个未经治疗的切除肿瘤碎块。在培养基中植板率...

嗜肺军团菌的发病机理与微生物检查及防治原则!
嗜肺军团菌是一种有鞭毛,革兰氏阴性,军团菌属多形态性的短小球...